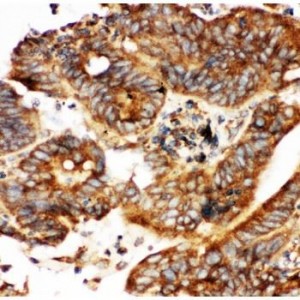
Calbindin  Antibody

Immunohistochemistry (IHC)
Showing 925–936 of 1068 resultsSorted by latest
-

Caldesmon(smooth) Antibody (monoclonal)
$330.00 Add to cart -

Calcineurin alpha Antibody (monoclonal)
$330.00 Add to cart -

Calbindin-D Antibody (monoclonal)
$330.00 Add to cart -
Calbindin Antibody
$365.00 Add to cart -

CA1 Antibody
$365.00 Add to cart -

C5a Antibody
$365.00 Add to cart -

C5/C5a Antibody
$330.00 Add to cart -

Bub3 Antibody
$330.00 Add to cart -

BTK Antibody
$365.00 Add to cart -

BRCA1 Antibody
$365.00 Add to cart -

Bonzo Antibody
$330.00 Add to cart -

Bone Sialoprotein Antibody
$330.00 Add to cart